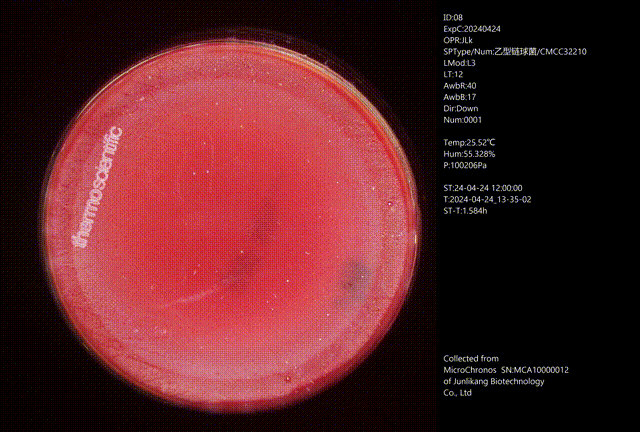

400-081-4789
400-081-4789

關(guān)注度:4992
英文名稱:暫無(wú)信息
產(chǎn)品貨號(hào):JLK(D)M034
產(chǎn)品規(guī)格:20mL*10皿/包*2/盒
產(chǎn)品用途:營(yíng)養(yǎng)非常豐富,用于各種細(xì)菌的基礎(chǔ)培養(yǎng)及純化培養(yǎng)
產(chǎn)品備注:暫無(wú)信息
電話:010-61227619 61228821 61228781
網(wǎng)址:www.sharebang00002.com.cn
郵箱:sale@junlikang.com
地址:北京市大興區(qū)海鑫路8號(hào)院1號(hào)廠房西側(cè)







